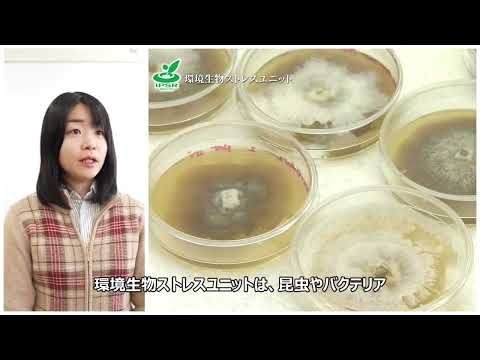
植物検疫製品の有効成分リスト - 定義

このリストは、有害生物から作物を保護するために使用される植物保護製品 (または植物保護製品、または殺虫剤) に含まれる主な活性物質を示しています。
これらの活性物質の中には、欧州で認可されているか評価待ちのものもあれば、欧州連合によって禁止されているものもあります。
1 – 2 – A – B – C – D – E – F – G – H – I – J – K – L – M – N – O – P – Q – R – S – T – U – V – W – X – Y – Z
— 1 —
- 1,3ジクロロプロペン

— 2 —
- 2.4 Dエステル
- 2.4Dジメチルアミン塩
- 2.4 DBエステル
- 2.4 DB ジメチルアミン塩
- 2.4 MCPAエステル
- 2.4 MCPA ジメチルアミン塩
- 2.4 MCPBナトリウム塩
- 2.4.5 Tアミン塩
– もっている –
- アバメクチン
- アセフェート
- アセトクロル
- アシベンゾアル-S-メチル
- アシフルオルフェン
- アクロニフェン
- アクリナトリン
- アラクロル
- アルディカーブ
- アロキシジムナトリウム
- アルファメトリン
- α-シペルメトリン
- アメトリン
- アミドスルフロン
- アミノトリアゾール
- アミトラズ
- アンシミドール
- アニラジン
- アントラキノン
- 亜ヒ酸ナトリウム
- アシュラメ
- アトラジン
- アジムスルフロン
- アジンホスメチル
- アゾシクロチン
- アゾキシストロビン
— B —
- ベナラキシル
- ベンディオカルブ
- ベンフルラリン
- ベンフラカルブ
- ベノミル
- ベノクサコル
- ベンスルフロンメチル
- ベンスルタップ
- ベンタゾン
- ベンゾキシメート
- ベタシフルトリン
- ビフェノックス
- ビフェントリン
- ビオレスメトリン
- ビテルタノール
- ブロディファカム
- ブロフェンプロックス
- ブロマシル
- ブロモホス
- ブロモプロピレート
- ブロモキシニル
- ブロムコナゾール
- ブピリメート
- ブプロフェジン
- ブトラリン
— C —
- カドゥサフォス
- キャプタン
- カルバリル
- カルベンダジム
- カルベタミド
- カルボフラン
- カルボフェノチオン
- カルボスルファン
- カルボキシン
- カルフェントラゾン
- キノメチオン酸
- 塩素酸ナトリウム
- クロルフェンビンホス
- クロリダゾン
- クロルメホス
- クロルメコート
- クロロフェニゾン
- クロロピクリン
- クロロタロニル
- クロロクスロン
- クロルプロファム
- クロルピリホスエチル
- クロルピリホスメチル
- クロルスルフロン
- クロルタール
- クロルチアミド
- クロルトルロン
- 塩化コリン
- シニドンエチル
- シノスルフロン
- チントフェン
- クレソディム
- クロジナホッププロパルギル
- クロフェンセット
- クロフェンテジン
- クロマゾン
- クロピラリド
- クロキントセットメキシル
- クマフェン
- シアナミド水素
- シアナジン
- シクロエート
- シクロキシジム
- シフルトリン
- シヘキサチン
- サイモキサニル
- シペルメトリン
- シプロコナゾール
- シプロジニル
- シロマジン
— D —
- ダラポン
- ダミノジド
- ダゾメット
- DCPA
- デルタメトリン
- デメトン-s-メチルスルホン
- デスメディファム
- デスメトリン
- ダイアジノン
- ディカンバ
- ディカンバ
- ジクロベニル
- ジクロフェンチオン
- ジクロフルアニド
- ジクロン
- ジクロロフェン
- ジクロルプロップ
- ジクロルプロップエステル
- ジクロルボス
- ジクロブトラゾール
- ジクロホップメチル
- ジコフォル
- ジノクロル
- ジエチオン
- ジエトフェンカルブ
- ジフェンアミド
- ジフェノコナゾール
- ディフェンゾクワット
- ジフルベンズロン
- ジフルフェニカニル
- ディケグラク
- ジメフロン
- ジメタクロル
- ジメテンアミド
- ジメチピン
- ジメトエート
- ディメトモーフ
- ジニコナゾール
- ディノキャップ
- ディノセブ
- ジフェニルアミン
- ジクワット
- ジスルホトン
- ジチアノン
- ジチオエート
- ジウロン
- DNOC
- ドーデモルフ
- ドグアディン
— え —
- エブフォス
- エンドスルファン
- エポキシコナゾール
- TCPS
- エスビオトリン
- エスフェンバレレート
- エテフォン
- エチジムロン
- エチオフェンカルブ
- エトフメセート
- エトプロフォス
- エチルモール
- エトフェンプロックス
— ふ —
- ファモキサドン
- フェナリモール
- フェナザキン
- フェンブコナゾール
- フェンブタチン
- フェンクロリム
- フェンフラム
- フェンヘキサミド
- フェニトロチオン
- フェニゾン
- フェノプロップ
- フェノキサプロップエチル
- フェノキサプロップ-p-エチル
- フェノキシカルブ
- フェンピクロニル
- フェンプロパトリン
- フェンプロピジン
- フェンプロピモルフ
- フェンピロキシメート
- フェンチオン
- 酢酸フェンチン
- 水酸化フェンチン
- フェンバレレート
- ファーバム
- フィプロニル
- フランプロップイソプロピル
- フランプロップM
- フラザスルフロン
- フルアジホップP
- フルアジホップ-p-ブチル
- フルアジナム
- フルジオキソニル
- フルフェナセット
- フルフェノクスロン
- フルメキン
- フルミオキサジン
- フルオログリコフェン
- フルポキサム
- フルピルスルフロン
- フルキンコナゾール
- フルリドン
- フルリドン
- フルオロクロリドン
- フルロキシピル
- フルルプリミドール
- フルルタモン
- フルシラゾール
- フルトラニル
- フルトリアフォール
- フォルペル
- フォメサフェン
- フォノフォス
- ギ酸塩
- 形成)
- フォサミンアンモニウム
- フォセチル –アルミニウム
- フララキシル
- フラチオカルブ
— G —
- グルホシネート
- グリホサート
— は —
- ハロキシホップ-エトキシエチル
- ハロキシホップR酸
- ヘプテノホス
- ヘキサコナゾール
- ヘキサフルムロン
- ヘキサジノン
- ヘキシチアゾックス
- ヒドラメチルノン
- マレイン酸ヒドラジド
- ヒメキサゾール

– 私 –
–J-
— K —
- クレソキシムメチル
— L —
— ま —
- マラチオン
- マンコゼブ
- マネブ
- メコプロップ
- メコプロップ
- メフェンピルジエチル
- メフルイジド
- メピコート
- メプロニル
- メルカプトジメチル
- メソトリオン
- メタラキシル
- メタアルデヒド
- メタミトロン
- メタムナトリウム
- メタザクロル
- メトコナゾール
- メタベンズチアズロン
- メタミドホス
- メチダチオン
- メトミル
- メトプレン
- メティラム亜鉛
- メトブロムロン
- メトラクロール
- メトスラム
- メトクスロン
- メトリブジン
- メトスルフロンメチル
- メビンフォス
- モリネート
- モナリド
- モノクロトフォス
- モノリヌロン
- ミクロブタニル
— N —
— O —
- オフラス
- オメトエート
- オリザリン
- オキサジアゾン
- オキサディキシル
- オキサミル
- オキシカルボキシン
- オキシデメトンメチル
- オキシフルオルフェン
— P —
- パクロブトラゾール
- パラコート二塩化物
- パラチオンエチル
- パラチオンメチル
- ペンコナゾール
- ペンシキュロン
- ペンディメタリン
- ペルメトリン
- フェナミホス
- フェンメディファム
- リン酸塩
- ホサロン
- ホサメチン
- ホスメット
- ホスファミドン
- フォキシム
- ピクロラム
- ピペロニルブトキシド
- ピリミホスメチル
- ポリオキシエチレンアミン
- プレチラクロール
- プロクロラズ
- プロシミドン
- プロフェノホス
- プロヘキサジオン
- プロメトリン
- プロパクロル
- プロパモカルブ
- プロパニル
- プロパキザホップ
- プロパルジャイト
- プロペタンフォス
- 予言する
- プロピコナゾール
- プロピネブ
- プロピザミド
- プロスルホカルブ
- プロスルフロン
- プロトエート
- ピメトロジン
- ピラフルフェンエチル
- ピラゾン
- ピラゾホス
- ピリダベン
- ピリダフェンチオン
- ピリジン酸
- ピリフェノックス
- ピリメタニル
- ピリミカルブ
- ピリプロキシフェン
— Q —
- キナルフォス
- クインクロラック
- キンメラック
- キノキシフェン
- キントゼン
- キザロホップ
— R —
- リムスルフロン
- ロテノン
— S —
— た —
- タウフルバリン酸塩
- テブコナゾール
- テブフェノジド
- テブフェンピラド
- 手ぶため
- テブチウロン
- テフルベンズロン
- テフルトリン
- テメフォス
- ターバシル
- テルブフォス
- テルブメトン
- テルブチラジン
- テルブトリン
- テトラコナゾール
- テトラジフォン
- テトラチオ炭酸ナトリウム
- チアベンダゾール
- チフェンスルフロンメチル
- チオシアン酸アンモニウム
- チオシアン酸ナトリウム
- チオジカルブ
- チオファノックス
- チオメトン
- チオファネートメチル
- チオファン
- ティラム
- トルクロホスメチル
- トリルフルアニド
- トラコキシディム
- トラロメトリン
- 三酢酸グアザチン
- トリアジメフォン
- トリアジメノール
- トライアルする
- トリアペンテノール
- トリアスルフロン
- トリアザメイト
- トリアゾキシド
- トリブヌロンメチル
- トリクロルホン
- トリクロピルエステル
- トリクロピルアミン塩
- トライデモルフ
- トリフルムロン
- トリフルラリン
- トリフルスルフロンメチル
- トリフォリン
- トリネキサパックエチル
- トリチコナゾール
— う —
— V —
- バミドチオン
- バーノレート
- ビンクロゾリン
— わ —
- ワルファリン
—
— はい —
— Z —

